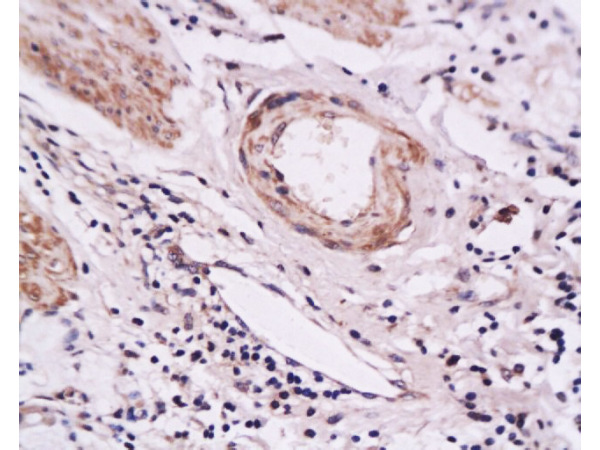
Formalin-fixed and paraffin embedded human gastric carcinoma tissue labeled with Anti-E-Selectin Polyclonal Antibody, Unconjugated(bs-1273R) at 1:200 followed by conjugation to the secondary antibody and DAB staining

Lane 1: DU145 cell lysates; Lane 2: LoVo cell lysates; probed with E-Selectin/CD62E Polyclonal Antibody, Unconjugated (bs-1273R) at 1:300 overnight at 4˚C. Followed by a conjugated secondary antibody at 1:10000 for 60 min at 37˚C.
E-Selectin Polyclonal Antibody
BS-1273R
ApplicationsFlow Cytometry, ImmunoFluorescence, Western Blot, ELISA, ImmunoCytoChemistry, ImmunoHistoChemistry, ImmunoHistoChemistry Frozen, ImmunoHistoChemistry Paraffin
Product group Antibodies
ReactivityHuman
TargetSele
Overview
- SupplierBioss
- Product NameE-Selectin Polyclonal Antibody
- Delivery Days Customer16
- ApplicationsFlow Cytometry, ImmunoFluorescence, Western Blot, ELISA, ImmunoCytoChemistry, ImmunoHistoChemistry, ImmunoHistoChemistry Frozen, ImmunoHistoChemistry Paraffin
- Applications SupplierWB(1:300-5000), ELISA(1:500-1000), FCM(1:20-100), IHC-P(1:200-400), IHC-F(1:100-500), IF(IHC-P)(1:50-200), IF(IHC-F)(1:50-200), IF(ICC)(1:50-200)
- CertificationResearch Use Only
- ClonalityPolyclonal
- Concentration1 ug/ul
- ConjugateUnconjugated
- Gene ID20339
- Target nameSele
- Target descriptionselectin, endothelial cell
- Target synonymsCD62E, E-selectin, ELAM-1, Elam, LECAM2, E-selectin, CD62 antigen-like family member E, endothelial leukocyte adhesion molecule 1, leukocyte-endothelial cell adhesion molecule 2
- HostRabbit
- IsotypeIgG
- Protein IDQ00690
- Protein NameE-selectin
- ReactivityHuman
- Storage Instruction-20°C
- UNSPSC12352203
References
- Zhang S, Wotzkow C, Bongoni AK, et al. Role of the plasma cascade systems in ischemia/reperfusion injury of bone. Bone. 2017,97:278-286. doi: 10.1016/j.bone.2016.12.007Read this paper
- Chou KJ, Lee PT, Chen CL, et al. CD44 fucosylation on mesenchymal stem cell enhances homing and macrophage polarization in ischemic kidney injury. Exp Cell Res. 2017,350(1):91-102. doi: 10.1016/j.yexcr.2016.11.010Read this paper